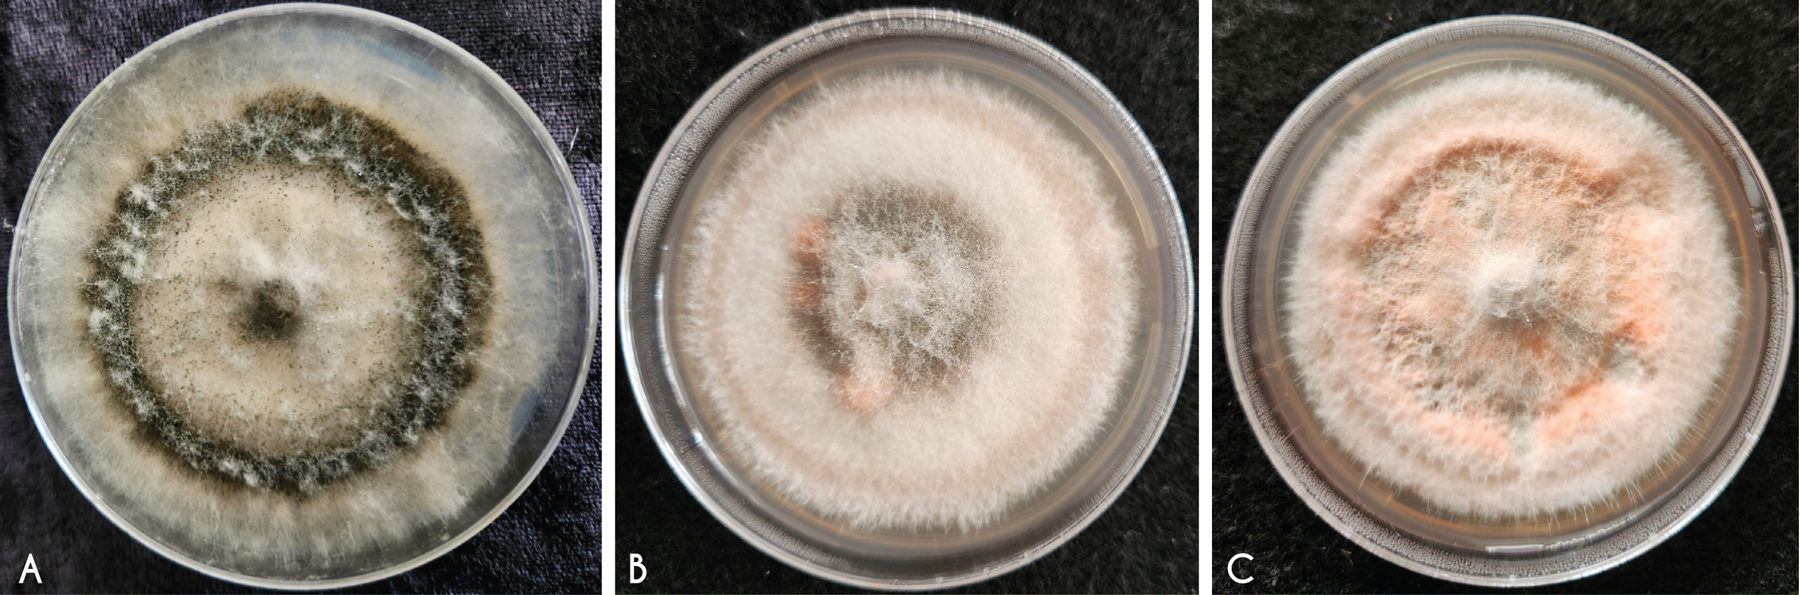
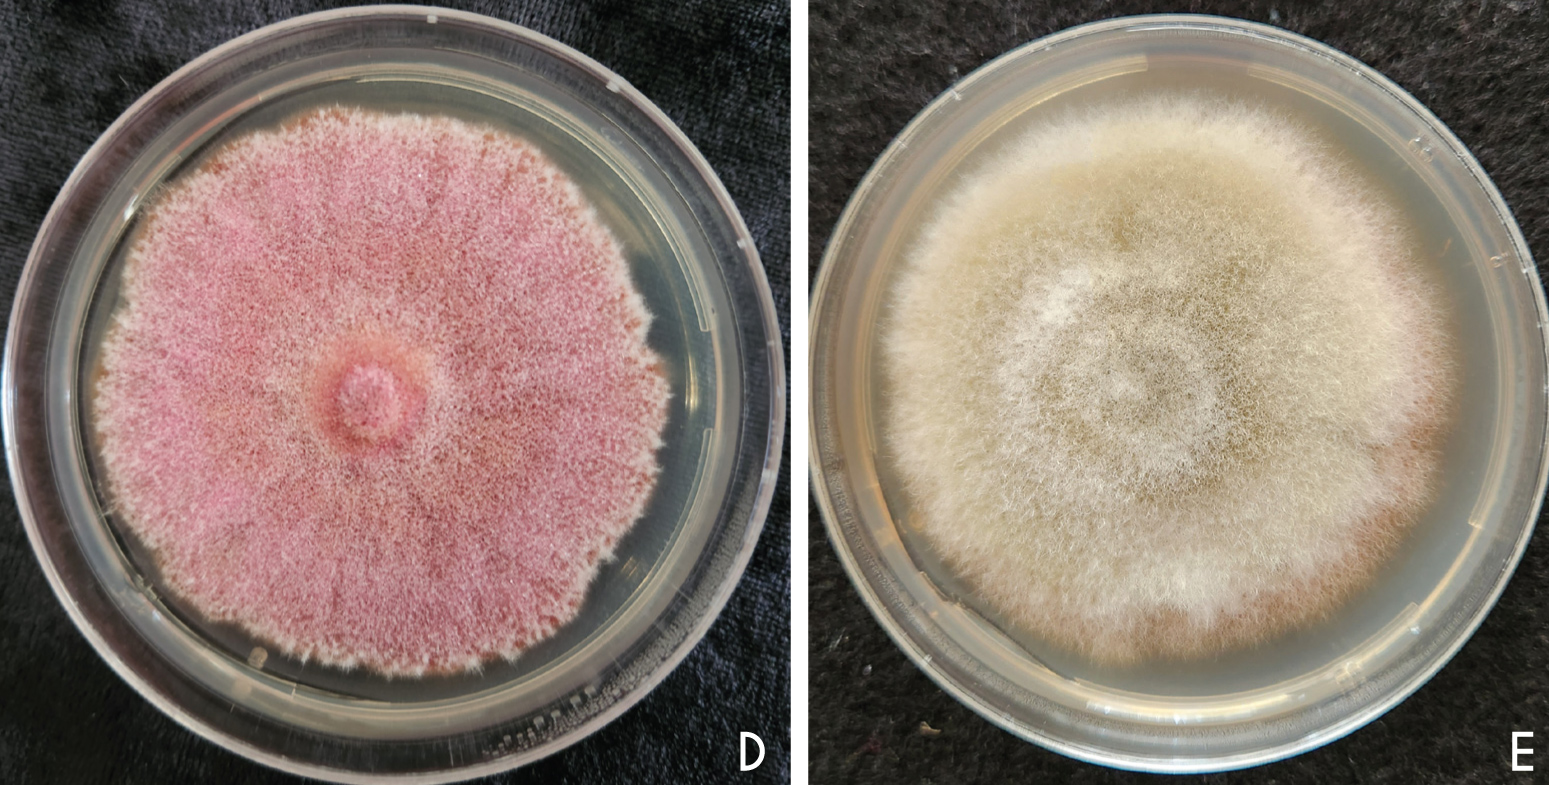

Sorghum is a climate-resilient grain crop known for its ability to withstand heat and drought stress. In South Africa, sorghum is produced on commercial and smallholder scale, predominantly in the drier parts of the summer rainfall region. While it is often perceived today as a staple for underprivileged communities, sorghum has a long history as a nutritious food source for human consumption.
Beyond household use, this hardy crop also plays a role in animal feed, beer brewing, and the manufacturing of value-added products. However, over the past decade, sorghum production has declined, largely due to changing consumer habits, as many households are opting for alternative staples, and a move by producers towards more commercially attractive crops such as maize and soybeans (USDA, 2021).
Additionally, the limited availability of sorghum cultivars with desirable agronomic traits has made production less appealing to producers. The pressure from and emergence of pests and pathogens further complicate production, especially as these are intensified by heat and moisture stress, possibly linked to climate change. Together, these challenges have contributed to a reduction in the area planted (Dunjana et al., 2022). In response to these challenges, the University of the Free State (UFS), in collaboration with the University of KwaZulu-Natal (UKZN) and industry partner Sorgho, is contributing to efforts aimed at improving sorghum through targeted pre-breeding and national disease surveillance initiatives. These partnerships aim to strengthen cultivar development and better understand emerging disease threats across production regions.
Sorghum is under threat from fungal diseases that reduce grain quality, limit producer profits, and impact food safety. Grain mold is a significant concern to sorghum production due to grain contamination by fungi that often result in significant yield or quality losses depending on cultivar, prevailing weather conditions, and the flowering period. The fungi associated with grain mold produce mycotoxins, toxins produced by fungi within the grain, which can pose health risks to both humans and animals when consumed (Jedidi et al., 2018).
First comprehensive dataset of fungi
It has been nearly three decades since fungal diseases of sorghum were documented in South Africa, through a disease compendium which was created for producers. As there has never been a national sorghum disease survey conducted, this has contributed to a gap in knowledge of the occurrence and distribution of fungal diseases. The Field Pathology & Epidemiology Research Group at UFS undertook research to uncover fungal pathogens that are present in harvested grain from both small-scale and commercial farms, as identifying these fungal pathogens is important in developing effective disease management strategies. Our aim is to provide the first comprehensive dataset of fungi associated with infected grain by collecting and analysing samples across regions and production systems.
Sorghum grains were sampled from smallholder and commercial farms across KwaZulu-Natal (KZN), Limpopo, and North West during a national sorghum disease survey in the growing season from March to April 2023. After surface-cleaning the infected grain to ensure that only internally borne fungi are identified, we placed the grain on selective agar plates to see which fungi would grow. The morphological features of the mycelium, both macroscopic and microscopic, were identified following the guidelines provided in the Compendium of Sorghum Diseases (Frederiksen and Odvody, 2000) and Soil and Seed Fungi (Watanabe, 2002). A total of 53 pure isolates were recovered from diseased sorghum grain from KZN and Limpopo. Unfortunately, the North West samples stored in the laboratory refrigerator were compromised by load-shedding, and we were therefore unable to analyse the isolates. The fungi were confirmed through molecular DNA techniques to characterise fungal pathogens. The percentage germination of the grain samples from each province was determined.
A total of 53 fungal isolates were successfully identified, representing eleven genera: Alternaria, Bipolaris, Curvularia, Dothideomycetes, Epicoccum, Exserohilum, Fusarium, Mucor, Nigrospora, Phoma and Trichoderma (Figure 1).

Six of these genera are frequently associated with grain mold, an important sorghum disease, particularly problematic in regions where high humidity coincides with the grain-filling stage. In commercial production in Roedtan, Limpopo, a grain mold epidemic occurred. In some cases, the severity of disease and fungal presence may appear exaggerated due to prior bird damage, which creates an entry point and favourable conditions for infection (Figure 2).

Grain mold is known to be associated with a fungal complex of more than 40 species (Forbes et al., 1992), including Bipolaris spp., Fusarium spp., Alternaria spp., Curvularia spp., Epicoccum spp., and Phoma spp., which were identified in our study. These pathogens are known to produce mycotoxins, particularly when weather conditions favour their growth, and their post-harvest impacts include compromised human and animal health. While the health risks are real, they typically arise when contaminated grain is eaten in significant amounts or over extended periods. Additionally, grain molds primarily affect grain quality, thereby reducing market and nutritional value, and are also associated with poorer grain filling, which results in reduced grain weight and ultimately yield loss (Khaskheli et al., 2025).
Fungal genera observed
Fungal genera varied significantly between Tugela Ferry (KZN) and Lebowakgomo (Limpopo). Each location yielded a unique set of fungal genera with no overlap between the two. In contrast, all eleven genera were identified in Roedtan (Limpopo), highlighting the high fungal diversity associated with the epidemic observed. Results of the present study suggest that agro-ecological zones have an influence on the type and distribution of fungal genera prevalent under different production environments and systems (Ngugi et al., 2002; Koima et al., 2022). The differences in fungal genera observed may also be due to temperature preferences, i.e., the temperature and rainfall conditions in Tugela Ferry, KZN (23 °C, 30-70 mm) are conducive for Alternaria sp. and Curvularia sp.
We observed that the germination percentage varied significantly between commercial and small-scale production. This is because commercial producers purchase new seeds (hybrids) with good and/or improved quality for every growing season, whereas small-scale farmers replant saved sorghum seed, often on the same land every year, leading to reduced germination due to the chances of innate pathogens (Koima et al., 2022). This is a barrier to production because of the loss of quality of seed during storage due to the growth of post-harvest fungi on grains (Dunjana et al., 2022; Szabo and Korosi, 2023).
By identifying the specific fungi affecting sorghum grain quality and germination in different regions and production systems, we can help producers choose better and effective disease management strategies. This information is critical for updating the compendium of sorghum diseases in South Africa. Ultimately, understanding mycotoxin risks also helps protect public health. This work is a step towards safer food systems and more resilient sorghum production under changing environmental conditions.

Findings
Our findings confirm that sorghum grain is susceptible to a wide range of fungal pathogens that vary depending on the region and production practices. Several of these fungi, such as Fusarium, Alternaria, and Phoma, are known to produce harmful mycotoxins that can affect both human and animal health. We aim to work with breeders to evaluate the newest sorghum pre-breeding programme lines and with extension officers to promote disease awareness and safe post-harvest handling among both small and commercial producers.
Inquiries regarding sorghum diseases can be directed to Thabiso Masisi (masisi.tv@gmail.com) and dr Lisa Rothmann (coetzeeLA@ufs.ac.za).
Acknowledgements
We gratefully acknowledge the support of the Department of Science, Technology and Innovation (DSTI), the Technology Innovation Agency (TIA), and Grain SA for providing postgraduate bursaries that enabled the training and development of emerging researchers involved in this study. We would also like to thank the National Research Foundation of South Africa for funding the running costs of this research through the Thuthuka Grant (grant no. TTK220323450).

























